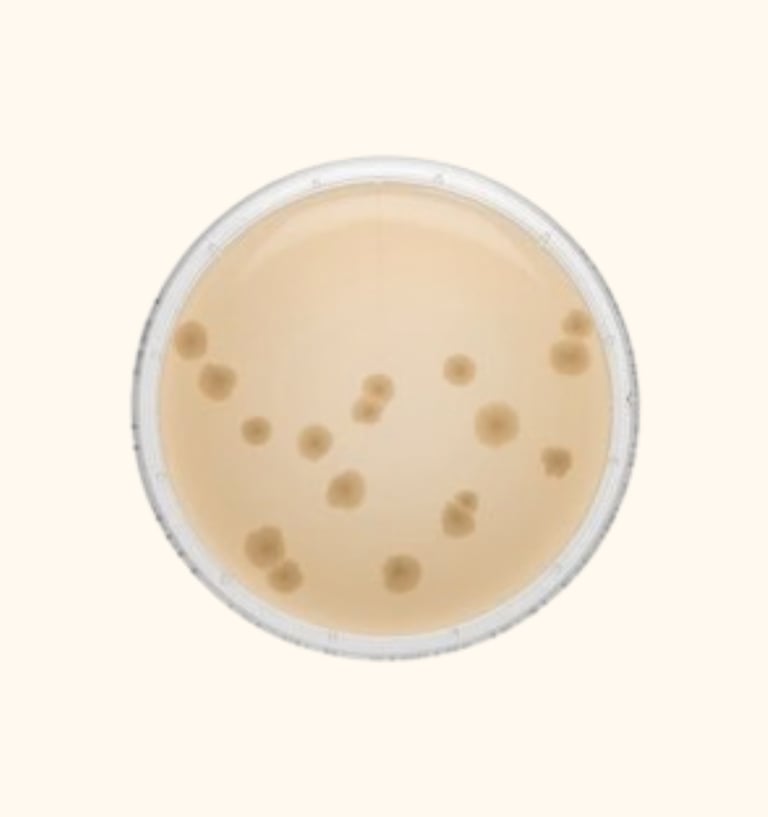
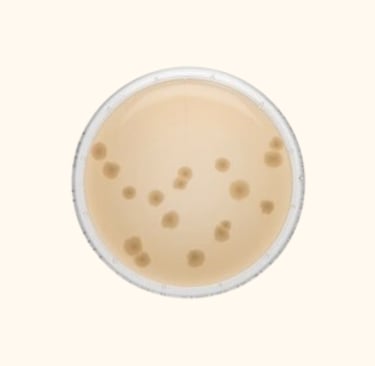
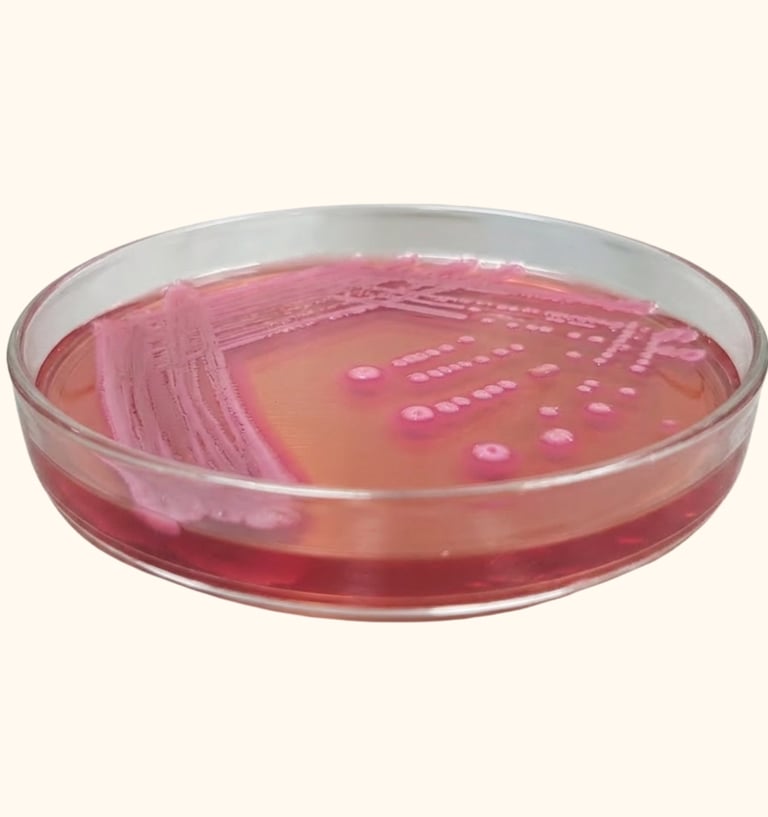
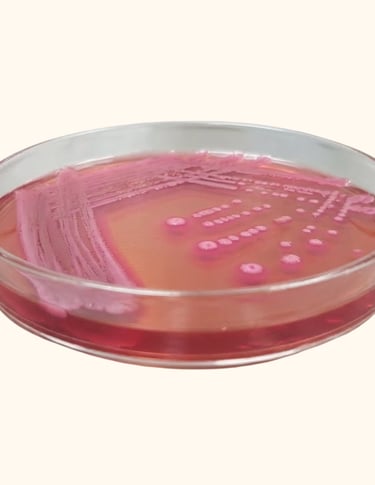
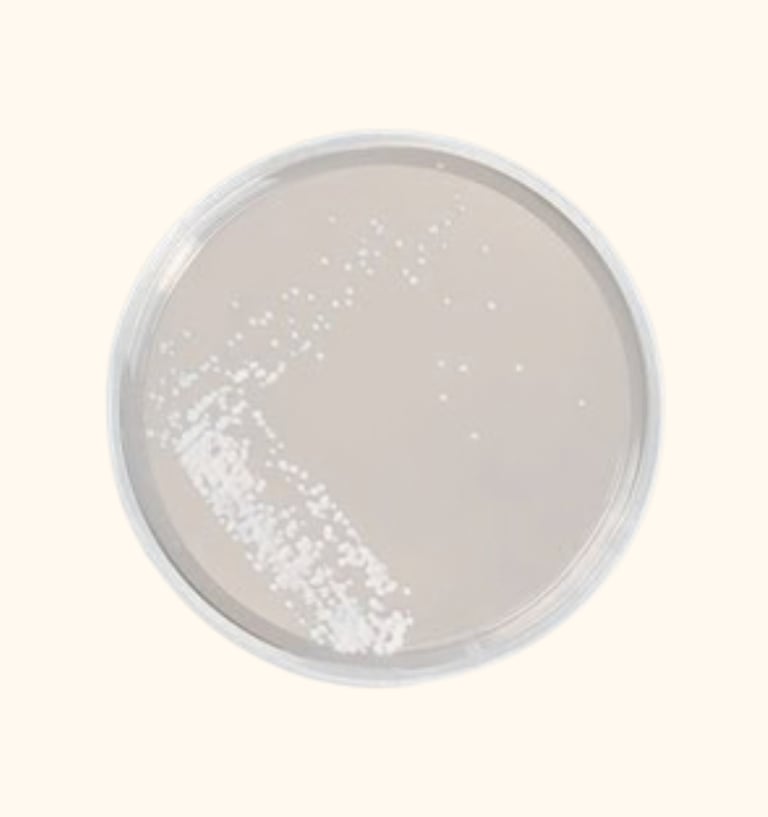
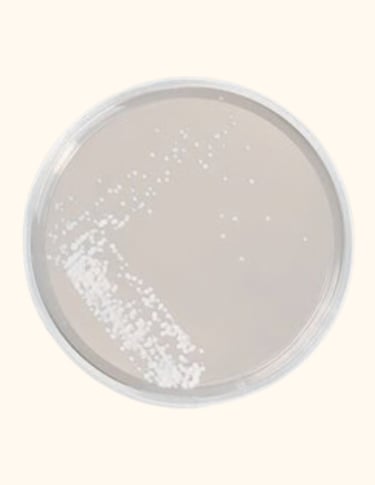
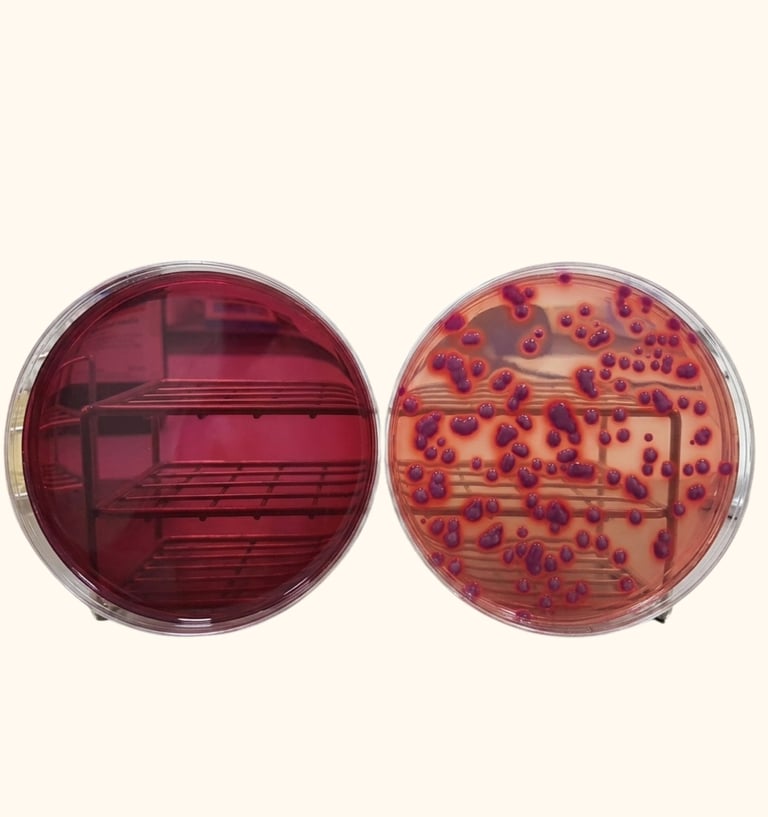
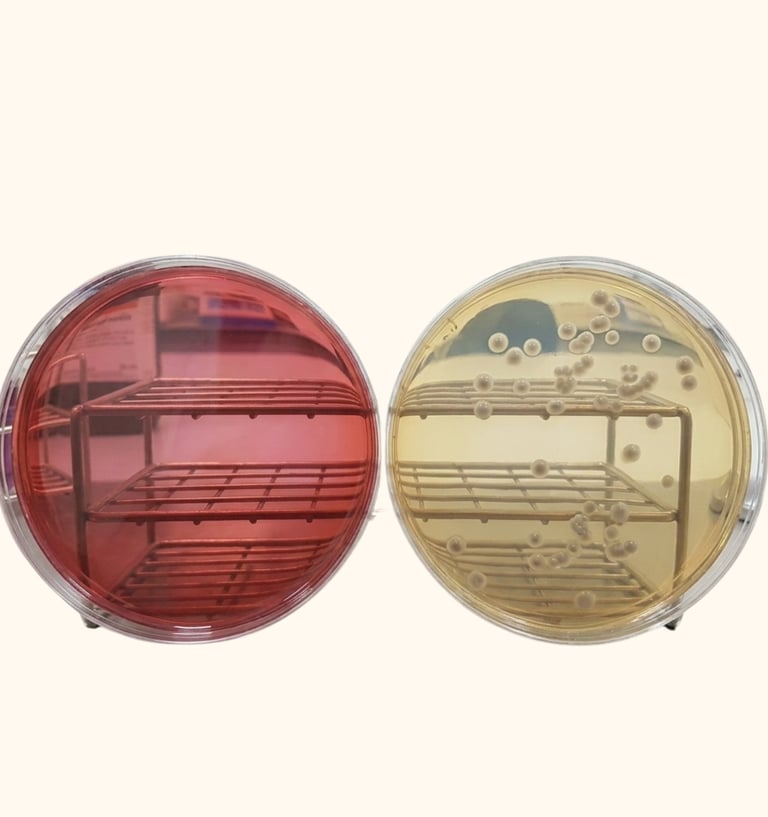
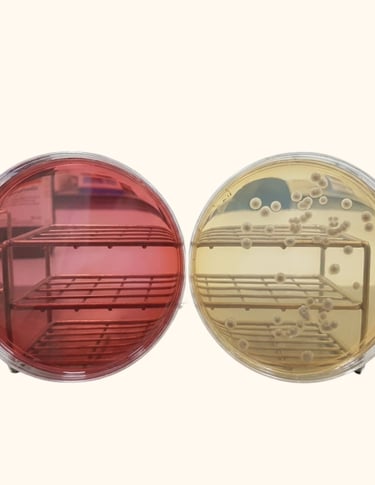

Microbiological Media
Provide a short description of categories listed below.
Tryptone Soya Agar

Tryptone Soya Agar Plate
Tryptone Soya Broth


Sabouraud Dextrose Agar




Enterobacteria Enrichment Broth
Mannitol Salt Agar (MSA)

MacConkey Agar

MacConkey Broth
Sabouraud Dextrose Agar Plate


Eosin Methyline Blue




Cetrimide Agar
Xylose Lysine Deoxycholate Agar


R2A Agar

Lactose Broth
Violet Red Bile Glucose Agar

Burkholderia Cepacian Agar
Coming Soon
Coming Soon
Request a Free Quotation
Please Fill up the below form and hit the submit button to get a free quotation.
Our expert will reach out to you as soon as possible!!